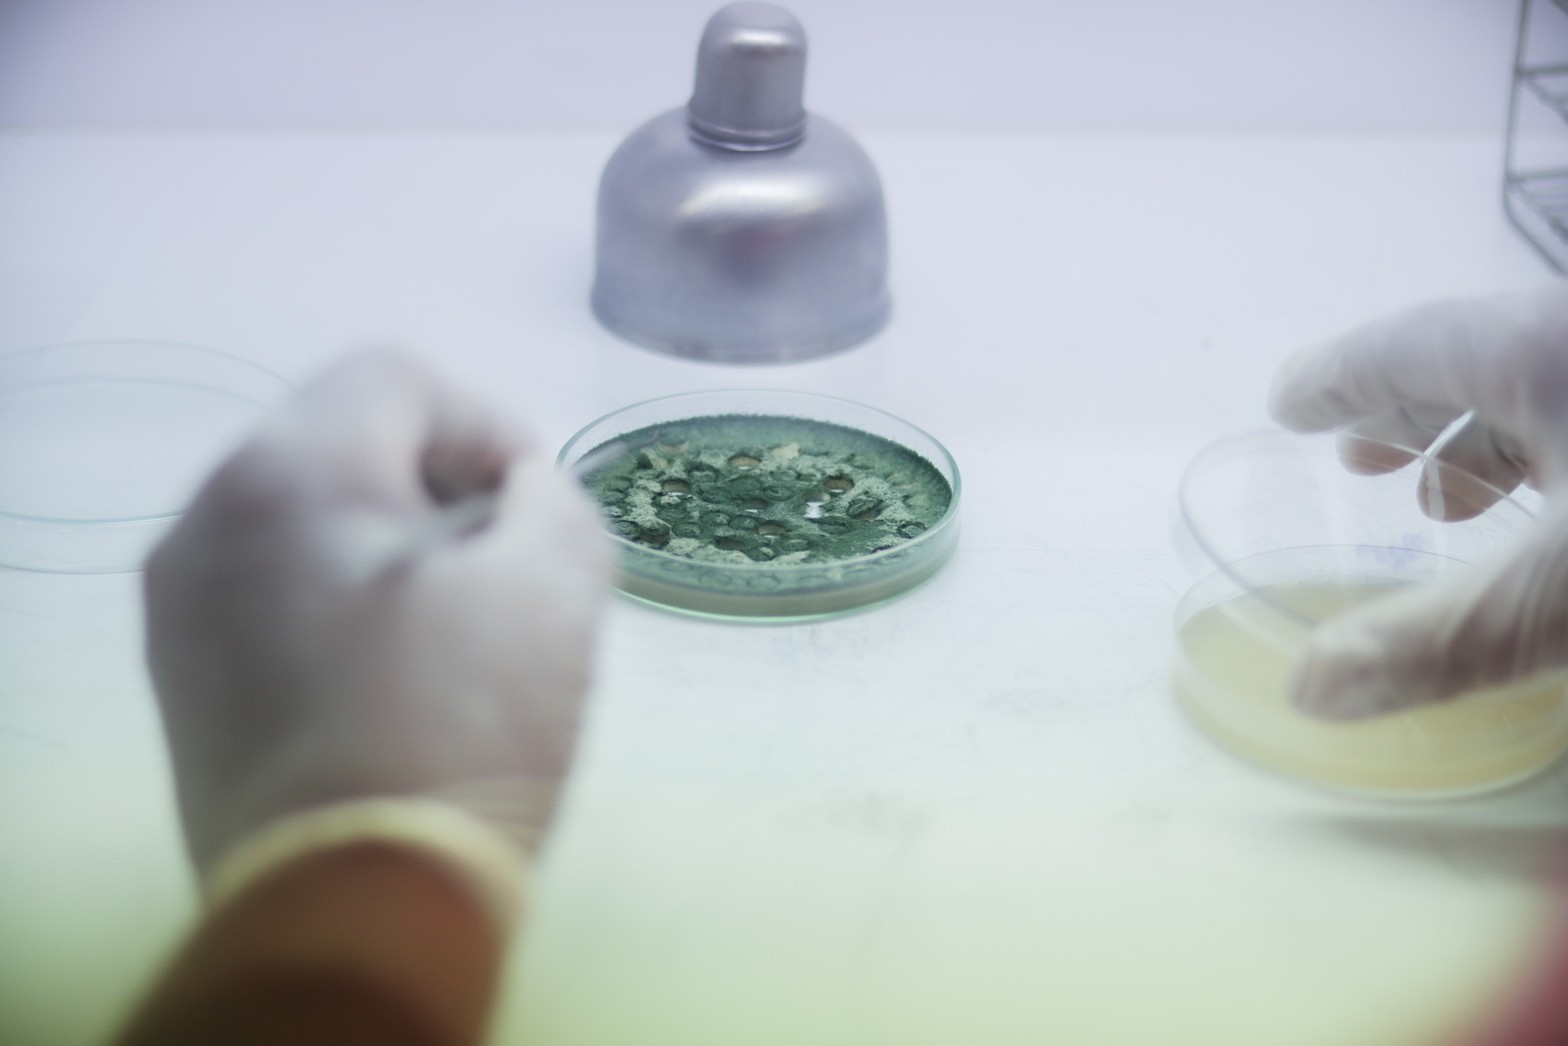

From Campus to Community: Walailak University’s Free Access to University Facilities for Sustainable Agriculture
Walailak University reaffirms its mission to contribute to community development and the grassroots economy. In 2024, the university provides free access to university facilities—including laboratories, technology, and plant stocks—to local farmers and food producers, particularly in Nakhon Si Thammarat Province, to improve sustainable farming practices.
Walailak University reaffirms its mission to contribute to community development and the grassroots economy. Based on diagnostics of local agricultural challenges, the university provides free access to university facilities—including laboratories, technology, and plant stocks—to local farmers and food producers, particularly in Nakhon Si Thammarat Province. Through this active engagement, the university supports the improvement of sustainable farming practices and empowers local communities to apply scientific knowledge in real-world contexts.
Free Access for Local Farmers

Opening Laboratories for Farmers to Improve Sustainable Farming Practices
Laboratories are a starting point for knowledge development, especially for sustainable farming practices that local farmers often lack access to. Walailak University therefore offers local farmers access to its laboratories free of charge.
Animal Feed Laboratory
The Animal Feed Laboratory, located at the Science and Technology Instruments Center 3, provides opportunities for local farmers to explore and gain knowledge that can be applied to their careers. Through hands-on experiments and learning about nutrient-rich raw materials, farmers improve sustainable livestock practices and reduce long-term costs. One key initiative is the workshop “Managing Quality Protein Ingredients for Animal Feeding,” which trains participants to enhance livestock productivity through efficient use of protein resources.






Another activity focuses on “Azolla and Black Soldier Fly (BSF),” where participants learn how to use local bio-resources. Azolla, a protein-rich aquatic plant, and BSF, a sustainable insect protein source, were introduced as alternative feed ingredients. Farmers gained hands-on experience in cultivation, processing, and practical applications on farms.








Free Technology Access for Local Farmer to Sustainable Farming Practices
Universities are centers of knowledge and technology—resources often inaccessible to local farmers without institutional support. Recognizing this, Walailak University grants free access to agricultural technologies to improve sustainable farming practices.
Bio-agents Technology
The university carries out proactive activities to promote local farmers’ access to bioproduct technologies by conducting field visits to transfer techniques for expanding bioproduct agents to the community. This enables farmers to produce and utilize bioproducts on their own at the farm level, reducing reliance on chemical pesticides while increasing opportunities for safe and environmentally friendly farming. This technology is not only an outcome of academic research but also a crucial mechanism that connects the university with actual production sectors, thereby strengthening food security and improving farmers’ quality of life in the long term.

The technology was developed by the Center of Excellence in Microbial Biotechnology. The bioproduct consists of five highly effective components:
(1) Trichoderma asperellum NST-009, a fungus that helps control plant diseases and promotes plant growth;
(2) Metarhizium anisopliae WU-003, a fungus with high efficacy in controlling up to 11 types of insect pests;
(3) Beauveria bassiana WU-002, a fungus capable of controlling 7 types of insect pests;
(4) the nutrients calcium and magnesium (CaMg(CO₃)₂), which strengthen plant cell walls and enhance resistance to pests; and
(5) a proprietary spore germination stimulator for antagonistic fungi, a trade-secret component that plays a crucial role in enhancing the overall effectiveness of the bioproduct.



Trichoderma asperellum
NST-009
Metarhizium anisopliae
WU-003
Beauveria bassiana
WU-002
In addition to its diverse biological efficacy, this bioproduct stands out for its application formats suited to agricultural contexts in various regions, including spore suspension, spore powder, spore granules, and bath bomb spores, all designed for ease and convenience of use. These formats are suitable for both small-scale farmers and community-level producers. Most importantly, the product has been certified for international safety standards by laboratories accredited with Good Laboratory Practice (GLP) and complies with the requirements of the Organization for Economic Co-operation and Development (OECD).




Hydroponics Technology
Another way to promote local farmers and food producers in improving sustainable farming practices is by providing free access to university technology, namely hydroponic technology, a method of growing plants without soil by using water enriched with dissolved nutrients. This approach helps save space and water, allows for easier control of growth factors, reduces problems related to plant diseases and pests, and results in clean, high-quality produce that can be grown year-round. Popular systems include NFT, DFT, DWC, and DRFT, which utilize basic equipment such as planting channels, water pumps, air pumps, AB fertilizer, growing media, planting cups, seeds, and pH-EC meters. The key steps involve seedling propagation, preparation of nutrient solutions, transplanting seedlings into the system, monitoring and managing growth factors, and harvesting once plants reach maturity. This represents a modern and sustainable alternative that aligns with the needs of contemporary agriculture.
Vegetable Cultivation in the 5G Era: Safe Hydroponic Production Practices
The project on safe hydroponic vegetable production emphasizes modern cultivation methods that ensure both efficiency and consumer safety. The key practices include:
- Selecting vegetable varieties that are suitable for the prevailing climatic conditions and market demand.
- Regulating pH and nutrient levels according to the growth stages of each crop.
- Avoiding the use of chemical pesticides by employing greenhouse structures with plastic covers and insect-proof nets.
- Reducing fertilizer application by using plain water where appropriate, while monitoring nitrate levels before harvest to ensure consumer safety (nitrate content must not exceed 2000 mg/kg).
- Implementing systematic production planning and maintaining related data records, such as temperature and light intensity, to optimize cultivation outcomes.




Additionally, the center provides hands-on demonstration programs designed to build practical skills for both students and farmers. One highlighted program on traditional rice farming guides participants through the entire rice cultivation cycle. Emphasizing organic practices, the center promotes the use of manure as fertilizer and biological pest control methods, ensuring high-quality, chemical-free rice production.
Rice cultivation today leverages a wide range of technologies, including modern machinery, smart farming innovations, and biotechnology, all aimed at increasing efficiency, reducing costs, and promoting sustainable practices.



- Machinery and Automation
- Agricultural drones: Used for field surveys, soil moisture measurement, and precise application of fertilizers and pesticides.
- Laser land leveling machines: Ensure uniform soil surfaces for efficient water distribution across fields.
- Rice transplanters/seedling spreaders: Enable consistent transplanting, reduce contamination, speed up cultivation.
- Combine harvesters: Improve harvesting efficiency and minimize crop loss.
- Smart Agriculture Technologies
- IoT and AI systems: Utilize sensors and cameras to collect data on soil conditions and crop health, enabling data-driven farm management.
- Satellites and digital platforms: Support systematic monitoring and management of cultivation areas.
- AI-based seed and grain quality inspection: Helps in selecting high-quality seeds and assessing rice quality with accuracy.
- Biotechnology (Agritech)
- Biodegradable bio-sheets: Applied to control weeds, reduce methane emissions, and enhance productivity.
- Smart greenhouses/plant factories: Provide controlled environments–managing light, temperature, humidity, and nutrients–for consistent, high-quality rice production.
Key Benefits of These Technologies
- Improve production efficiency and yield
- Reduce unnecessary costs such as labor, fertilizers, and weed control
- Minimize environmental impacts, particularly methane emissions
- Make rice farming easier, faster, more convenient, and more sustainable




Free Plant Stocks Access for Local Farmers to Sustainable Farming Practices


For local farmers, plant stocks are a crucial component of their livelihood, as they represent the starting point of future yields and, consequently, their income. With its diverse collection of plant species, the Walailak University Botanic Park serves as a valuable resource, providing free access to university plant stocks to study, learn, and apply this knowledge to enhance local farmer professions and improve sustainable farming practices. The parks highlights three key areas for provision of plant stock access as follows:
Bamboo Garden
This area serves as a model site for collecting and showcasing a wide variety of bamboo species, including both local and imported varieties. Its purpose is to provide a learning resource on bamboo biodiversity, as well as to serve as a database for research, development, and promotion. Local farmers are encouraged to build upon this knowledge for economic purposes, such as using it as construction material, or processing it into community products.


Herbal Garden
This is another important learning resource, open to students, farmers, and the general community to visit and explore a wide variety of medicinal plants. It provides knowledge about their properties, cultivation, care, and everyday uses. The knowledge gained can be appropriately applied to the cultivation and utilization of medicinal plants within households or community settings.








Free Access for Food Producers

Opening Laboratories for Food Producers
For food producers, the kitchen is one of the most essential elements in the food production process. Therefore, the university has provided local food producers with free access to its food laboratories.
Food Laboratories at Walailak Culinary Training Center
The Walailak Culinary Training Center is fully equipped in every aspect, including facilities, kitchens, equipment and tools, theory classrooms, and specialized personnel. These resources allow local food producers to access its laboratory for learning and to further develop their professions. Access to the laboratories is provided through training programs under academic service projects and other channels, enabling local food producers to practice culinary skills and develop processed food products such as:
The Organic Spotted Mackerel Curry Sauce Making Workshop
This workshop not only aimed to enhance the value of local raw materials and serve as a guideline for generating additional income for food producers, but also provided participants with the opportunity to access high-quality equipment from a food preparation laboratory.






This workshop encourages the community to utilize local marine resources, such as blue crabs, to create unique signature dishes. This not only adds value to food products but also enhances culinary skills for commercial purposes by accessing university food preparation laboratories.
The Blue Swimming Crab Dumplings and Blue Swimming Crab Spring Rolls Making Workshop







Free Technology Access for Food Producers to Sustainable Farming Practices
Walailak University recognizes the importance of technology in supporting food producers, especially local farmers, community enterprises, and small entrepreneurs. Access to advanced processing technologies is offered through hands-on workshops, ensuring practical applications. Key technologies include:
Technology for Protein Ingredient Management and Quality Improvement
Under the workshop on “Management of Quality Protein Raw Materials for Animal Feed,” the university provides free access to university technology to food producers for analyzing the nutritional composition of plants and insects, processing technologies to enhance nutritional value, and technologies for developing specialized animal feed formulations. Altogether, these technologies enable food producers to create high-quality animal feed, which serves as a primary source of raw materials for food production, while reducing reliance on imported ingredients and lowering long-term production costs.


Technology for Cultivation and Utilization of Azolla
Azolla is a high-protein aquatic plant that serves as an alternative protein source and can be cultivated in closed systems without requiring large areas of land. Recognizing its benefits, the university organized a workshop on “Azolla and Black Soldier Fly (BSF)” to provide local food producers with access to cultivation technologies, efficient farming system management, and processing techniques for use as animal feed ingredients or as new types of processed food raw materials. This initiative enhances the capacity of food producers by equipping them with sustainable, environmentally friendly production technologies that support the bioeconomy.







Free Plant Stocks Access for Food Producers to Improve Sustainable Farming Practices
Walailak University is committed to conserving and disseminating knowledge on plant biodiversity related to food production through the development of key plant genetic resource collections that can serve as primary raw materials for food production. These collections are made accessible to local food producers in an organized and convenient manner. The learning resources aim to encourage the application of knowledge for the production and development of food products in a creative and sustainable way. The following key areas are open for visits and study:


Banana Garden
The Banana Garden houses a collection of more than 100 local and rare banana varieties from Thailand, such as Kluai Sao Krathuep Ho, Kluai Nam Nom, Kluai Nak, Kluai Roi Hwi, Kluai Chang, Kluai Thepparos, Kluai Phama Haek Khuk, and Kluai Nom Sao. Each banana variety has distinctive characteristics in terms of taste, aroma, and suitability for processing into a wide range of food products. This garden therefore serves both as a center for plant genetic conservation and as a learning resource that inspires food producers to recognize the potential of local raw materials.





Pitcher Plant Greenhouse
The Pitcher Plant Greenhouse showcases a wide variety of carnivorous plants, particularly pitcher plants, which are rare forest species. The collection includes common varieties such as round-leaf and narrow-leaf pitcher plants, as well as rare species such as Golden Cup and Large-leaf pitcher plants. These exhibits help enhance knowledge of ecosystem biodiversity and can be further developed into innovative culinary menus or food products that incorporate pitcher plants as either primary or supplementary ingredients.






WU Botanic Park
The Botanic Park gathers plant species from various regions with potential for food utilization. Examples include cinnamon, which can be used as a spice and medicinal herb; santol, a local fruit commonly prepared as desserts or beverages; and kloi (Dioscorea hispida), which requires processing before safe consumption. These plants serve as a learning resource that encourages food producers to apply knowledge in developing new food products or preserving traditional recipes that rely on indigenous ingredients.



Kla Dee Center
The Kla Dee Center supplies food producers with premium organic plant stocks cultivated through hydroponic systems and insect-protected greenhouses. Growing entirely without chemicals, these plant stocks meet stringent standards for both domestic and international markets. By offering these university plant stocks free of charge to food producers, Walailak University supports them in delivering safe, sustainable, and chemical-free food products that align with growing consumer demand.




Smart Farm
It serves as a collection of diverse plant varieties, offering food producers opportunities to study, gain hands-on experience, and access plant stocks such as durian, jackfruit, santol, aromatic coconut, mangosteen, salacca, banana, and Tubtim Siam pomelo, among others. These plants can be used in food production, enabling producers to learn cultivation processes and apply the knowledge to advance their own businesses.




In summary, this initiative by Walailak University demonstrates how university facilities and technologies can be effectively utilized to enhance sustainable farming practices. Continuous measurement of outcomes ensures that the interventions remain relevant and impactful. Ultimately, the initiative reflects the university’s long-term commitment to agricultural development, directly addressing the needs of farming communities and driving Thailand toward becoming a leader in sustainable agriculture.
In summary, this initiative by Walailak University represents an excellent example of how the university facilities (e.g. labs, technologies, and plant stocks) to local farmers and food producers can be applied to improve sustainable farming practices. It directly addresses the needs of agricultural communities and plays a vital role in driving Thailand toward becoming a leader in sustainable agriculture in the future.
Related links:
https://cas.wu.ac.th/archives/36482
https://cas.wu.ac.th/archives/36498
https://cas.wu.ac.th/archives/36510
https://cas.wu.ac.th/archives/36523
https://cas.wu.ac.th/archives/36533
https://cas.wu.ac.th/archives/28630
https://cas.wu.ac.th/archives/28577
https://e-bota.wu.ac.th/location/33
Goal 2: Zero hunger
Goal 1: No poverty
Goal 4: Quality Education
Goal 17: Partnerships for the Goals

